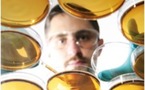
Lancement du 2ème appel à projets de recherche &amp; développement

|
5006 Résultats pour votre recherche : budget-(h87.cc)-budget->>h87.cc
Création d’une Direction Générale des Finances PubliquesConseil des Ministres | 15/06/2011 | Actualité de Tahiti et ses îles
Le président de l'APF a rempli le caddie de "Solidarité pour tous"() | 09/06/2011 | Actualité de Tahiti et ses îles
Nouvelles tranches de CST : le recours devant le Conseil d'Etat est suspensifF K | 31/05/2011 | Actualité de Tahiti et ses îles
Réforme du statut: Temaru met en garde contre l'abréviation du mandat des représentantsF K | 30/05/2011 | Actualité de Tahiti et ses îles
1 ha de terrains militaires cédés à Arue dès juincommuniqué | 26/05/2011 | Actualité de Tahiti et ses îles
Observatoire du BTP : les professionnels sont "plus qu'inquiets"F K | 24/05/2011 | Actualité de Tahiti et ses îles
Les communes de Polynésie française se tournent vers l’Europe pour leur financementF K | 23/05/2011 | Actualité de Tahiti et ses îles
L'assemblée instaure un ticket modérateur pour les patients en longue maladieF K | 19/05/2011 | Actualité de Tahiti et ses îles
Sandra Manutahi Lévy-AGAMI fait la lumière sur les salaires de la fonction publiqueSandra MANUTAHI LEVY-AGAMI | 12/05/2011 | Actualité de Tahiti et ses îles
Conseil municipal de Faa'a: adoption du compte administratifCommunication ville de FAAA | 11/05/2011 | Actualité de Tahiti et ses îles
Lancement du 2ème appel à projets de recherche & développementcommuniqué Tahiti Fa'ahotu | 11/05/2011 | Actualité de Tahiti et ses îles
Le GIE Tahiti Tourisme à la recherche de nouveaux financementsF K | 11/05/2011 | Actualité de Tahiti et ses îles
Rumeurs sur la fermeture de TNTV : Yves Haupert défend sa chaîneF K | 09/05/2011 | Actualité de Tahiti et ses îles
The Brando : l’éco-hôtel fonctionnera avec 100% d’énergies renouvelablesF K | 06/05/2011 | Actualité de Tahiti et ses îles
|
|
|||
|
TAHITI-INFOS est un site édité par FENUACOMMUNICATION Sarl au capital de 20 000 000 Fcfp, immeuble Manarava - Shell RDO Faa'a - BP 40160 98 713 Papeete Polynésie Française.
(+689) 40 43 49 49 - Dir. de publication : Sarah MOUX - Gérant : Albert MOUX |
||||